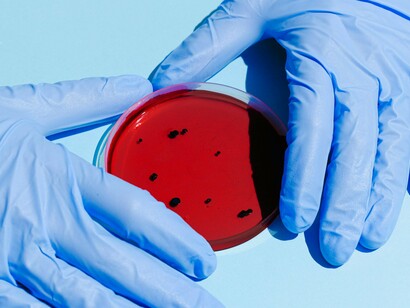
Cultura de bactérias. A. muciniphilia é enriquecida na camada de muco do revestimento intestinal<sup>7</sup>. Tal como outras bactérias intestinais saudáveis, produz ácidos gordos de cadeia curta através da fermentação de fibras alimentares. Também decompõe as glicoproteínas chamadas mucinas e desempenha um papel significativo na manutenção da barreira intestinal e na regulação imunitária. Ou seja, as mucinas são uma classe de proteínas que são revestidas com muitos açúcares. Criam uma barreira física que protege as células epiteliais de danos, agentes patogénicos e irritantes

Há um tipo de poluentes orgânicos persistentes denominados substâncias per e polifluoroalquil (PFAS, per- and polyfluoroalkyl substances) 1. São uma classe de produtos químicos que as empresas adicionam a uma grande variedade de produtos de consumo para torná-los antiaderentes, impermeáveis e resistentes a manchas.
Há mais de 9.000 diferentes produtos químicos PFAS atualmente, fazendo com que esta seja a substância sintética mais fácil de encontrar no mundo. São substâncias químicas sintéticas que têm sido utilizadas em produtos de consumo desde a década de 1950. Estavam presentes em muitos produtos. Por exemplo, os PFAS têm sido utilizados para evitar que os alimentos se colem às embalagens ou aos utensílios de cozinha, para tornar as roupas e as alcatifas resistentes às manchas e para criar espuma de combate a incêndios mais eficaz.
Um relatório dos Centros de Controlo e Prevenção de Doenças dos EUA encontrou PFAS no sangue de 97% das pessoas nos EUA2. Os PFAS podem aumentar o risco de diabetes tipo 2. Provocam danos ambientais e são tóxicos para o fígado, o sistema imunitário neuroendócrino, os rins, os pulmões e o sistema cardiovascular3. São especialmente perigosos para fetos e crianças em desenvolvimento4.
Têm sido utilizados em produtos de consumo desde a década de 1950. Têm sido utilizados para evitar que os alimentos se colem às embalagens ou aos utensílios de cozinha, para tornar as roupas e as alcatifas resistentes às manchas e para criar espuma de combate a incêndios mais eficaz. Têm um grupo terminal polar (como o COOH) e uma cadeia de carbonos com átomos de flúor ligados a eles em ligações covalentes. Como a ligação carbono-flúor é uma das mais fortes, estes químicos não se degradam facilmente no ambiente. Dois deles, o ácido perfluorooctanóico e o sal de sódio do ácido perfluorossulfónico foram retirados dos produtos de consumo no início da década de 2000. São os chamados PFAS antigos. Foram misturados com politetrafluoroetileno (também conhecido como Teflon, fabricado pela Tefal) e utilizados em utensílios de cozinha antiaderentes.
Os PFAS podem diminuir a função renal e aumentar o risco de cancro dos rins. Concentrações relativamente elevadas de PFAS no sangue podem aumentar o colesterol total, os triacilgliceróis (também conhecidos como triglicéridos) e as lipoproteínas de baixa densidade. Todos estes são factores de risco para doenças cardiovasculares. Quando os PFAS se acumulam no sangue, as plaquetas podem promover a formação de coágulos sanguíneos. A inalação de PFAS pode causar inflamação no trato respiratório. A exposição profissional a quantidades relativamente elevadas de PFAS aumenta o risco de cancro do pulmão. Os PFAS podem prejudicar o desenvolvimento dos pulmões. Os PFAS podem interagir com outros poluentes, como o amianto e os microplásticos, tornando-se mais tóxicos.
Por isso, foi uma óptima notícia quando os investigadores descobriram recentemente que algumas das bactérias encontradas nos microbiomas intestinais humanos saudáveis absorvem rapidamente, bioacumulam e excretam PFAS no material fecal5. Isto inclui várias espécies do género Bacteroides: B. caccae, B. clarus, B. dorei, B. stercoris, B. thetaiotaomicron, e B. uniformis. Outras bactérias que removem PFAS incluem Odoribacter splanchnicus, Parabacteroides distasonis, Parabacteroides merdae e Escherichia coli. Estas bactérias podem eliminar os PFAS mesmo quando estes estão presentes em concentrações baixas.
Além disso, existe uma bactéria saudável do intestino humano chamada Akkermansia muciniphila que ajuda a prevenir a obesidade e várias doenças humanas, incluindo a diabetes. Fá-lo através de uma rede coordenada de antigénios microbianos, lípidos, enzimas e metabolitos, enquanto o seu nível aumenta no intestino. Recentemente, foi demonstrado que também apoia a imunidade antiviral nos pulmões quando estes estão infectados com o vírus SARS-CoV-2 que causa a COVID-196. Ou seja, o microbioma intestinal está ligado aos pulmões através de várias vias de sinalização, tráfico de células imunitárias e metabolitos microbianos.
O vírus SARS-CoV-2 altera a composição e a diversidade do microbiota intestinal, tornando-o desequilibrado e pouco saudável. Isto pode levar a perturbações na integridade da barreira intestinal, a alterações nos metabolitos bacterianos, à translocação de bactérias e vírus para a corrente sanguínea e à hiperactivação das respostas imunitárias e inflamatórias. Estas são as principais caraterísticas da COVID-19 grave. As estratégias terapêuticas que visam o microbiota intestinal incluem a suplementação com ácidos gordos de cadeia curta e probióticos, bem como o transplante de microbiota fecal. Estas estratégias têm demonstrado resultados promissores no restabelecimento da homeostase microbiana e na modulação das respostas imunitárias em várias doenças infecciosas.
A. muciniphilia é enriquecida na camada de muco do revestimento intestinal7. Tal como outras bactérias intestinais saudáveis, produz ácidos gordos de cadeia curta através da fermentação de fibras alimentares. Também decompõe as glicoproteínas chamadas mucinas e desempenha um papel significativo na manutenção da barreira intestinal e na regulação imunitária. Ou seja, as mucinas são uma classe de proteínas que são revestidas com muitos açúcares. Criam uma barreira física que protege as células epiteliais de danos, agentes patogénicos e irritantes.
Algumas mucinas podem interagir com outras moléculas nas superfícies celulares, influenciando o comportamento e a comunicação das células. As quantidades de mucina e as alterações na sua estrutura estão associadas a vários tipos de cancro, incluindo os do trato gastrointestinal e da mama. As mucinas desempenham um papel em condições inflamatórias, como as que afectam as vias respiratórias (asma, bronquite). Podem ser alvos de agentes patogénicos, mas também podem ajudar a proteger contra as infecções. Além disso, a A. muciniphilia é resistente a muitos antibióticos. Assim, o microbioma intestinal está parcialmente protegido dos antibióticos.
A dieta afecta a estrutura, a composição e a função do microbioma intestinal humano. Os efeitos da dieta em A. muciniphila começam quase imediatamente após o nascimento. Um estudo recente investigou o impacto do metabolito betaína derivado do leite materno na abundância relativa global de A. muciniphila. Verificou-se que a betaína materna aumenta transitoriamente a sua abundância. Os oligossacáridos do leite humano, que são prebióticos para a microbiota intestinal neonatal, também promovem a expansão de A. muciniphila. Por outro lado, a ingestão de gorduras saturadas presentes na carne diminui a quantidade de A. muciniphila e de outras bactérias intestinais saudáveis. Os antioxidantes da dieta, o ácidos gordos de cadeia curta butirato e os hidratos de carbono complexos encontrados na fibra alimentar aumentam a abundância relativa de A. muciniphila.
Foi observada uma maior abundância de A. muciniphila no intestino de indivíduos saudáveis em comparação com indivíduos com distúrbios metabólicos, e vários benefícios metabólicos, incluindo um melhor controlo da glicose, redução da gordura corporal e redução da inflamação, foram associados à A. muciniphila. Assim, a fibra alimentar na dieta mediterrânica e outras é muito saudável. Além disso, uma das melhores coisas que pode fazer pela sua saúde e pela saúde de Gaia (a biosfera) é evitar comer carne - especialmente carne de vaca e de porco produzida em massa.
Notas
1 PFAS Exchange.
2 Lewis, R.C. et al. Serum biomarkers of exposure to perfluoroalkyl substances in relation to serum testosterone and measures of thyroid function among adults and adolescents from NHANES 2011–2012. International Journal of Environmental Research & Public Health. 2015. Volume 12, p. 6098–6114.
3 Bline, Abigail P., et al. Public health risks of PFAS-related immunotoxicity are real. Current Environmental Health Reports 11.2 (2024): 118-127.
4 Sodani, Kamlesh, et al. Toxicological mode-of-action and developmental toxicity of different carbon chain length PFAS. Toxicology Letters 405 (2025): 59-66.
5 Lindell, Anna E., et al. Human gut bacteria bioaccumulate per-and polyfluoroalkyl substances. Nature Microbiology (2025): 1-18.
6 Kim, Gi-Cheon, et al. Akkermansia Muciniphila Primes Lung-Resident Antiviral Immunity via the Gut–Lung Axis During SARS-CoV-2 Infection.
7 Aja, E. et al. Health effects and therapeutic potential of the gut microbe Akkermansia muciniphila. Nutrients 17.3 (2025): 562.